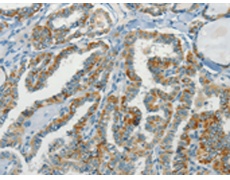
一抗

中文名稱: 兔抗NPAP1多克隆抗體
英文名稱: Anti-NPAP1 rabbit polyclonal antibody
別 名: C15orf2
相關(guān)類別: 一抗
儲(chǔ) 存: 冷凍(-20℃)
宿 主: Rabbit
抗 原: NPAP1
反應(yīng)種屬: Human
標(biāo) 記 物: Unconjugate
克隆類型: rabbit polyclonal
技術(shù)規(guī)格
|
Background: |
This gene is located in the Prader-Willi syndrome region on chromosome 15. This gene is biallelically expressed in adult testis and brain but is paternally imprinted in fetal brain. Defects in this gene may be associated with Prader-Willi syndrome. |
|
Applications: |
ELISA, IHC |
|
Name of antibody: |
NPAP1 |
|
Immunogen: |
Synthetic peptide of human NPAP1 |
|
Full name: |
nuclear pore associated protein 1 |
|
Synonyms: |
C15orf2 |
|
SwissProt: |
Q9NZP6 |
|
ELISA Recommended dilution: |
1000-5000 |
|
IHC positive control: |
Human thyroid cancer |
|
IHC Recommend dilution: |
50-200 |

 購物車
購物車 幫助
幫助
 021-54845833/15800441009
021-54845833/15800441009